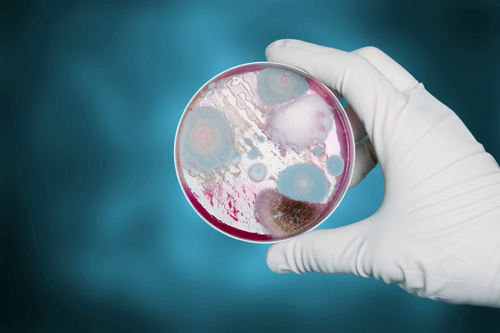

Plusieurs communications à l’ERS 2023 ont abordé les relations entre les microbiotes respiratoire et digestif. Le Pr Ubags (Lausanne, Suisse) a fait la synthèse des éléments utiles à la compréhension des relations mutuelles entre l’hôte et les agents infectieux aux niveaux intestinal et pulmonaire (1). A partir du tube digestif, des métabolites issus de modifications du microbiote intestinal par des bactéries ou des modifications du régime alimentaire (par exemple un régime privilégiant les fibres) peuvent avoir une influence sur l’immunité d’autres organes, notamment le poumon et son propre microbiote. Le taux circulant d’acides gras à chaîne courte pourrait également intervenir dans ces interactions entre microbiotes.
Microbiote intestinal et asthme de l’enfant
Un exemple concret a été fourni par le Dr Yuan Gao (Geelong, Australie) qui a présenté une étude consacrée à la relation entre le niveau de maturation du microbiote intestinal (MI) de jeunes enfants et le développement ultérieur d’un asthme infantile (2). L’étude Barwon Infant Study (BIS) a recruté 1 074 nouveau-nés entre 2010 et 2013 et étudie actuellement leur devenir depuis la naissance.
Les fèces recueillies 1, 6 et 12 mois après la naissance des enfants ont été analysées. Les parents ont été interrogés pour enregistrer la survenue éventuelle de manifestations asthmatiques à l’âge de 1 et de 4 ans. Des prick-tests ont été réalisés vis-à-vis de 10 catégories d’aliments, d’une plante fourragère (l’ivraie) et de la poussière. Dans un sous-groupe de 323 enfants un séquençage de l’ADN du microbiote a été réalisé pour caractériser le MI et calculer le score MAZ qui est une estimation mathématique de la maturité du MI.
Pour une augmentation d’une déviation standard du MAZ à l’âge de 1 an, les auteurs retrouvent une diminution de la probabilité pour l’enfant de présenter des manifestations respiratoires asthmatiques aussi bien à 1 an (rapport de risque [RR] = 0,51, intervalle de confiance à 95% [IC95] 0,36 – 0,71, p < 0,001) qu’à 4 ans (RR = 0,52, IC95 0,31 – 0,87, p = 0,01). Les résultats n’étaient pas significatifs sur les prélèvements à 1 mois et 6 mois. Les auteurs concluent qu’à partir de l’âge de 1 an, plus le MI est mature, moins l’enfant a de risques de présenter des manifestations respiratoires asthmatiques. Ce gain de chance pourrait être de l’ordre de 50 %.
De l’influence des mycobactéries sur le microbiote intestinal
Un autre travail, bien différent, était présenté par le Dr Shu (Taipei, Taiwan) (3). L’étude concerne l’influence des modifications du MI par les mycobactéries non tuberculeuses (MNT) dans un modèle murin. Les souris étaient infectées par des prélèvements fécaux issus de malades porteurs d’infection à MNT. La conséquence observée sur le MI était la diminution du taux de bactéries du genre Prevotella ce qui induirait la diminution de l’activation des lymphocytes de type TLR2, importants dans la protection anti-infectieuse. L’administration orale ultérieure de bactéries du genre Prevotella restaurait ces anomalies.
De ces travaux on peut ainsi conclure avec le Dr Ubags (1) que nombre d’affections respiratoires notamment infectieuses semblent associées à des modifications du MI. On retiendra également que des modifications du régime alimentaire par exemple au cours de la grossesse (ce qui pourrait être le cas dans le travail du Dr Gao) ou pour la prise en charge de l’obésité (compte tenu des liens entre la sévérité de l’asthme et l’obésité) pourraient aussi avoir des conséquences sur l’atopie respiratoire.
Dr Bertrand Herer